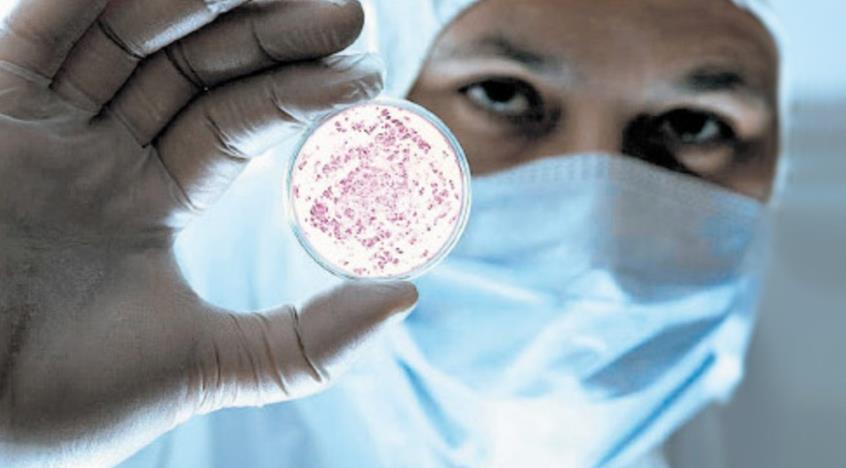

Ευχάριστα νέα για την 17χρονη κοπέλα που είχε γεννήσει στο Νοσοκομείο Χανίων και στη συνέχεια υπέστη σηπτικό σοκ λόγω βαριάς φλεγμονής. Είναι μια χαρά στην υγεία της και απολαμβάνει όμορφες στιγμές με το μωράκι της, αφήνοντας όλα τα άσχημα πίσω της.
Η κοπέλα, βγήκε σήμερα από τη ΜΕΘ, όπου νοσηλεύονταν όλο αυτό το διάστημα και μεταφέρθηκε στη Χειρουργική Κλινική αναφέρει το ρεπορτάζ της ΕΡΤ.

Ο Διοικητής του Νοσοκομείου Χανίων Γιώργος Μπέας, συνεχάρη το ιατρικό και νοσηλευτικό προσωπικό της ΜΕΘ, τους χειρουργούς, τους γυναικολόγους και τους αναισθησιολόγους, για την μάχη που έδωσαν προκειμένου να βγει νικήτρια η νεαρή μητέρα.
Οι αγωνιώδης προσπάθειες των γιατρών να σώσουν τη μητέρα από το σηπτικό σοκ
Η νεαρή λεχώνα έδωσε γενναία μάχη για να ξεπεράσει το βαρύτατο πρόβλημα υγείας. Από τις 17 Δεκεμβρίου όταν παρουσίασε σηπτικό σοκ, μετά τη γέννηση της κόρης της, μέχρι και σήμερα η 17χρονη παρέμενε στην εντατική, με τους δικούς της ανθρώπους να προσεύχονται ώστε αυτή η αναπάντεχη περιπέτεια να ολοκληρωθεί όσο το δυνατόν γρηγορότερα.
Τι είναι το σηπτικό σοκ
Το σηπτικό σοκ είναι περιστατικό πτώσης της πίεσης και ανεπαρκούς αιμάτωσης των οργάνων του αίματος ως απόρροια σήψης, δηλαδή εισόδου παθογόνων μικροοργανισμών στο αίμα.
Υπεύθυνοι γι’ αυτό μπορεί να είναι μύκητες ή άλλα βακτήρια. Αποτελεί ένα από τα στάδια του συνδρόμου συστηματικής φλεγμονώδους αντίδρασης.
Πού οφείλεται το σηπτικό σοκ
Το σηπτικό σοκ οφείλεται κυρίως σε λοίμωξη του αίματος μετά από είσοδο σε αυτό μυκήτων, ιών, βακτηρίων και παθογόνων μικροοργανισμών. Επίσης, μπορεί να οφείλεται σε λοίμωξη μετά από χειρουργική επέμβαση.

Συμπτώματα για το σηπτικό σοκ
Το νόσημα εκδηλώνεται με συμπτώματα:
Ζάλη
Πυρετός
Ρίγη
Υπόταση
Σύγχυση
Αστάθεια
Εμετός
Θεραπεία για το σηπτικό σοκ
Η θεραπεία του έγκειται στη χορήγηση της κατάλληλης φαρμακευτικής αγωγής, συνήθως με τη λήψη αντιβιοτικών. Ο γιατρός συνιστά άμεση αναπλήρωση υγρών με ενδοφλέβια μορφή ή χορήγηση αγγειοσυσταλτικών για να σταθεροποιηθεί το αίμα. Για να αποφευχθούν τυχόν βλάβες συνιστάται η χορήγηση οξυγόνου και άλλες υποστηρικτικές παρεμβάσεις.

Καλά λένε ότι η έγκυος γυναίκα είναι με το ένα πόδι στον τάφο κατά τη διάρκεια του τοκετού. Παρόλα αυτά όμως η 17χρονη τα κατάφερε μια χαρά και τώρα το μόνο που την νοιάζει είναι το να βρίσκεται συνέχεια μαζί με το μωράκι της. Τα άλλα δεν τα αναφέρει καν μιας και αποτελούν βαθιά πληγή για την ίδια.








